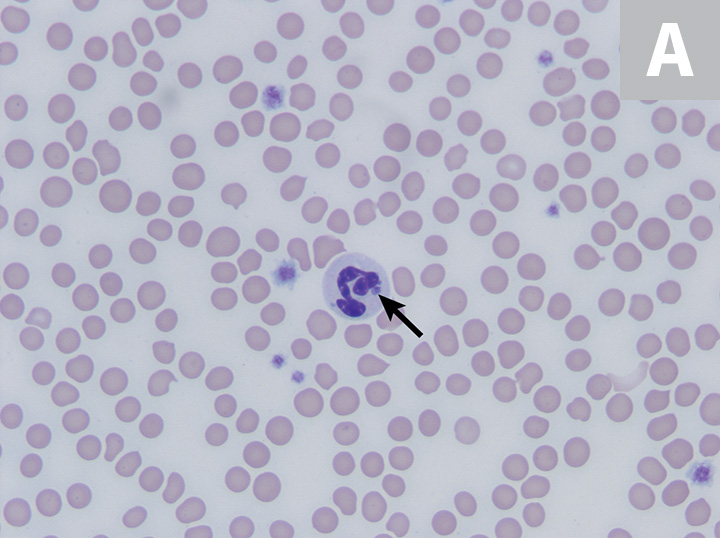

Anaplasmosis treatment in dogs on sale
Anaplasmosis treatment in dogs on sale, Anaplasma platys in Bone Marrow Megakaryocytes of Young Dogs on sale
$92.00
SAVE 50% OFF
$46.00
$0 today, followed by 3 monthly payments of $15.33, interest free. Read More
Anaplasmosis treatment in dogs on sale
Anaplasma platys in Bone Marrow Megakaryocytes of Young Dogs
Anaplasmosis in Dogs and Cats Is Tick Borne Veterinary Partner VIN
Anaplasmosis Symptoms Treatment in Dogs New Jersey Emergency
Granulocytic Anaplasmosis
Anaplasmosis in dogs
Anaplasmosis in dogs Agriculture and Food
Description
Product code: Anaplasmosis treatment in dogs on sale
Anaplasmosis in Dogs and Cats Is Tick Borne Veterinary Partner VIN on sale, Anaplasmosis Symptoms Treatment in Dogs New Jersey Emergency on sale, Granulocytic Anaplasmosis on sale, Anaplasmosis in dogs on sale, Anaplasmosis in dogs Agriculture and Food on sale, Anaplasmosis in Dogs Causes Symptoms Treatment Charlotte Vet on sale, Anaplasmosis in Dogs Causes Symptoms Treatment Providence on sale, Granulocytic Anaplasmosis on sale, Anaplasmosis in Dogs Causes Symptoms and Treatment on sale, Anaplasmosis in Dogs Lithia Springs Vets on sale, Anaplasmosis in Dogs Another Tick Borne Threat American Kennel Club on sale, IDEXX case study Anaplasmosis in a dog IDEXX Canada on sale, Canine Anaplasmosis Learn about Basic Symptoms Diagnosis on sale, Veterinary Sciences Free Full Text Epidemiology Diagnosis on sale, Anaplasmosis on sale, Tick Fever in Dogs Signs and Treatment of Babesia and Ehrlichia on sale, Anaplasmosis Wikipedia on sale, Parasitology Expertise from the NCVP Canine Tick Borne Diseases on sale, Veterinary Sciences Free Full Text Epidemiology Diagnosis on sale, What is Anaplasmosis in Dogs What Are The Long Term Effects on sale, Anaplasmosis in Ruminants Circulatory System MSD Veterinary Manual on sale, Canine Anaplasmosis causes Joint Pain and Stiff Legs in Dogs on sale, Anaplasma platys infected platelets in blood smear from a dog on sale, Anaplasmosis Symptoms in Dogs How This Disease is Treated on sale, Guideline for veterinary practitioners on canine ehrlichiosis and on sale, Causes Symptoms And Treatment Of Anaplasmosis In Dogs on sale, Anaplasmosis in Cats and Dogs Petful on sale, Anaplasmosis in Dogs What It Is Symptoms How It s Treated on sale, Anaplasmosis in Dogs Great Pet Care on sale, Anaplasmosis Symptoms in Dogs Southeast Memphis Vet on sale, What is Anaplasmosis in dogs and how is it treated Carolina on sale, Anaplasma eClinpath on sale, First case of Anaplasma platys infection in a dog from Croatia on sale, The Reality of Anaplasmosis in Dogs Carrollton Vets on sale, About Anaplasmosis in Dogs Palmdale Vets on sale, Anaplasmosis in Dogs Causes Symptoms Treatment Gainesville Vets on sale, Dog Tick Diseases on the Rise Ehrlichiosis and Anaplasmosis on sale, Anaplasmosis Symptoms in Dogs Cave Creek Vet on sale, Tick Borne Diseases Lyme Anaplasmosis in Dogs Davidson County Vet on sale, What Is Anaplasmosis in Dogs Louisa Vets on sale, Anaplasmosis In Dogs Causes Symptoms Treatment Petmoo on sale, What You Need To Know About Anaplasmosis In Dogs on sale, Anaplasmosis in Dogs Animal Hospital at Thorndale INC on sale, Anaplasmosis in Dogs Monterey Park Vets on sale, Giemsa stained smears of dogs Arrows demonstrating neutrophils on sale, Anaplasmosis in Dogs PetMD on sale, What Is Anaplasmosis in Dogs Whole Dog Journal on sale, Clinical and Laboratory Diagnosis Anaplasmosis CDC on sale, Anaplasmosis Cornell University College of Veterinary Medicine on sale, Anaplasma platys in Bone Marrow Megakaryocytes of Young Dogs on sale.
Anaplasmosis in Dogs and Cats Is Tick Borne Veterinary Partner VIN on sale, Anaplasmosis Symptoms Treatment in Dogs New Jersey Emergency on sale, Granulocytic Anaplasmosis on sale, Anaplasmosis in dogs on sale, Anaplasmosis in dogs Agriculture and Food on sale, Anaplasmosis in Dogs Causes Symptoms Treatment Charlotte Vet on sale, Anaplasmosis in Dogs Causes Symptoms Treatment Providence on sale, Granulocytic Anaplasmosis on sale, Anaplasmosis in Dogs Causes Symptoms and Treatment on sale, Anaplasmosis in Dogs Lithia Springs Vets on sale, Anaplasmosis in Dogs Another Tick Borne Threat American Kennel Club on sale, IDEXX case study Anaplasmosis in a dog IDEXX Canada on sale, Canine Anaplasmosis Learn about Basic Symptoms Diagnosis on sale, Veterinary Sciences Free Full Text Epidemiology Diagnosis on sale, Anaplasmosis on sale, Tick Fever in Dogs Signs and Treatment of Babesia and Ehrlichia on sale, Anaplasmosis Wikipedia on sale, Parasitology Expertise from the NCVP Canine Tick Borne Diseases on sale, Veterinary Sciences Free Full Text Epidemiology Diagnosis on sale, What is Anaplasmosis in Dogs What Are The Long Term Effects on sale, Anaplasmosis in Ruminants Circulatory System MSD Veterinary Manual on sale, Canine Anaplasmosis causes Joint Pain and Stiff Legs in Dogs on sale, Anaplasma platys infected platelets in blood smear from a dog on sale, Anaplasmosis Symptoms in Dogs How This Disease is Treated on sale, Guideline for veterinary practitioners on canine ehrlichiosis and on sale, Causes Symptoms And Treatment Of Anaplasmosis In Dogs on sale, Anaplasmosis in Cats and Dogs Petful on sale, Anaplasmosis in Dogs What It Is Symptoms How It s Treated on sale, Anaplasmosis in Dogs Great Pet Care on sale, Anaplasmosis Symptoms in Dogs Southeast Memphis Vet on sale, What is Anaplasmosis in dogs and how is it treated Carolina on sale, Anaplasma eClinpath on sale, First case of Anaplasma platys infection in a dog from Croatia on sale, The Reality of Anaplasmosis in Dogs Carrollton Vets on sale, About Anaplasmosis in Dogs Palmdale Vets on sale, Anaplasmosis in Dogs Causes Symptoms Treatment Gainesville Vets on sale, Dog Tick Diseases on the Rise Ehrlichiosis and Anaplasmosis on sale, Anaplasmosis Symptoms in Dogs Cave Creek Vet on sale, Tick Borne Diseases Lyme Anaplasmosis in Dogs Davidson County Vet on sale, What Is Anaplasmosis in Dogs Louisa Vets on sale, Anaplasmosis In Dogs Causes Symptoms Treatment Petmoo on sale, What You Need To Know About Anaplasmosis In Dogs on sale, Anaplasmosis in Dogs Animal Hospital at Thorndale INC on sale, Anaplasmosis in Dogs Monterey Park Vets on sale, Giemsa stained smears of dogs Arrows demonstrating neutrophils on sale, Anaplasmosis in Dogs PetMD on sale, What Is Anaplasmosis in Dogs Whole Dog Journal on sale, Clinical and Laboratory Diagnosis Anaplasmosis CDC on sale, Anaplasmosis Cornell University College of Veterinary Medicine on sale, Anaplasma platys in Bone Marrow Megakaryocytes of Young Dogs on sale.